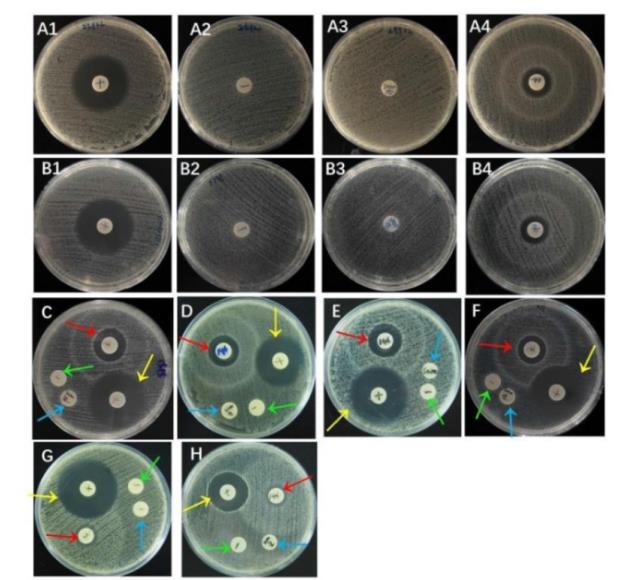
林氏扇頭蜱抗菌肽重組蛋白對大腸埃希菌生長曲線影響及抑菌效果（一）

選取雙元調(diào)控系統(tǒng)lmo1508/lmo1509進(jìn)一步研究發(fā)現(xiàn),在非脅迫和金屬離子脅迫條件下雙元調(diào)控系統(tǒng)lmo1508/lmo1509缺失株的gsh-p ...
歡迎來到BioSense網(wǎng)站!
歡迎來到BioSense網(wǎng)站!

選取雙元調(diào)控系統(tǒng)lmo1508/lmo1509進(jìn)一步研究發(fā)現(xiàn),在非脅迫和金屬離子脅迫條件下雙元調(diào)控系統(tǒng)lmo1508/lmo1509缺失株的gsh-p ...

本研究通過絲裂霉素C成功誘導(dǎo)出攜帶耐藥基因blaCTX-M-27的P1-CTX噬菌體-質(zhì)粒,其效價(jià)為106 PFU·mL-1,耐強(qiáng)堿而不耐強(qiáng)酸,且其對 ...

噬菌體的裂解周期,其增殖過程包括五個(gè)階段,分別為吸附、核酸注入、DNA合成、噬菌體粒子組裝和裂解細(xì)胞釋放。噬菌體的吸附、增殖和裂解可用一步生長曲線描述 ...

P1噬菌體-質(zhì)粒作為腸桿菌科細(xì)菌抗生素耐藥基因的載體受到人們的關(guān)注,本研究旨在探究攜帶抗生素耐藥基因的P1噬菌體-質(zhì)粒是否具有誘導(dǎo)和進(jìn)一步轉(zhuǎn)導(dǎo)等生物學(xué) ...

130株NTS對氨基糖苷類抗菌藥物(慶大霉素和阿米卡星)的敏感率僅20%左右,對環(huán)丙沙星的敏感率為43.1%,對復(fù)方磺胺甲惡唑的敏感率為50.8%,對 ...

目的了解成都市兒童侵襲性非傷寒沙門菌(non-typhoidal Salmonella,NTS)腸炎的臨床特征和耐藥情況,為臨床合理用藥和經(jīng)驗(yàn)治療提供 ...

從生長曲線中可看出,空白對照組在培養(yǎng)2 h后進(jìn)入快速對數(shù)生長期,并于9 h時(shí)達(dá)到穩(wěn)定期。相比之下,1/8×MIC處理組雖能抑制大腸埃希菌的生長,但抑制 ...

對各供試菌株的MIC及MBC結(jié)果表明,重組蛋白對大腸埃希菌及沙門菌具有較高的抑菌活性,除E.coli K88外,最小抑菌濃度均在0.625 mg/mL ...

選擇大腸埃希菌ATCC25922作為指示菌,取菌懸液與重組蛋白混合,使其終濃度分別為1/8 MIC、1/4 MIC、1/2 MIC、1 MIC,不加重 ...
目的探究林氏扇頭蜱抗菌肽Microplusin-like基因的抗菌功能,為了解林氏扇頭蜱先天免疫系統(tǒng)和開發(fā)蜱類防控藥物、新型抗菌藥物替代提供新的參考依 ...